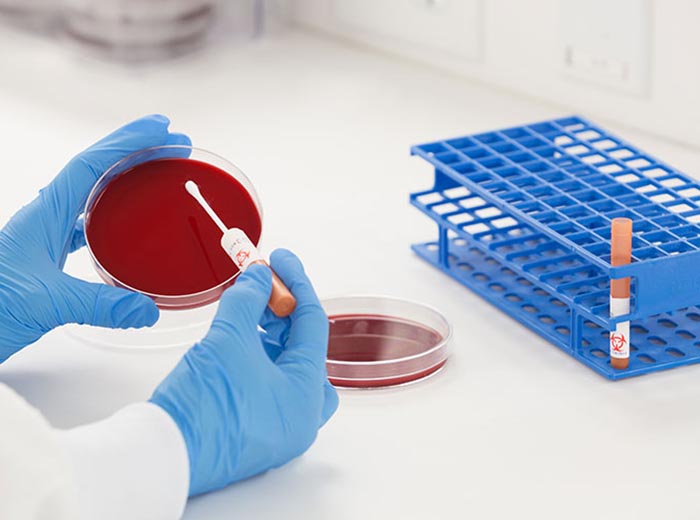
ATCC菌株

正確維護質(zhì)量控制菌株對于確保可接受的性能至關(guān)重要��。綠谷商貿(mào)生產(chǎn)的大多數(shù)菌株在正確維護的情況下�����,在重組后可使用長達一個月����。遵循以下這些更佳實踐和我們的維護計劃����,以保護您的ATCC菌株的活力、純度以及基因型和表型特征���。
微生物菌株應(yīng)在非選擇性瓊脂上開始,例如胰蛋白酶大豆瓊脂或羊血瓊脂�。不推薦使用肉湯,因為很容易引入污染物��。我們推薦的培養(yǎng)方法文件列出了個別物種的培養(yǎng)基要求���。每個菌株的培養(yǎng)方法也可以在我們網(wǎng)站的產(chǎn)品頁面上找到�。要維護微生物菌株,請遵循帖子末尾的維護計劃���。
大多數(shù) QC 微生物可以在非選擇性瓊脂平板或斜面上在室溫或冰箱中保存長達 4 周。1��、4
挑剔的微生物比需氧細菌的存活期更短����。這些菌株需要每隔幾天進行傳代培養(yǎng)。例如����,肺炎鏈球菌和淋病奈瑟菌需要每三天傳代一次�。
我們發(fā)現(xiàn)以下存儲條件有利于維護:
需氧菌:儲存在 2°- 8°C。在室溫下儲存時���,一些芽孢桿菌可以保持更長時間的活力。
CO 2依賴物種:在室溫下儲存在蠟燭罐或裝有 CO 2包的容器中���。
酵母菌和真菌:在室溫下儲存���。
厭氧菌:在室溫下儲存在厭氧條件下����。
彎曲桿菌 在微需氧條件下��,在 35°C 下儲存在巧克力瓊脂上��。